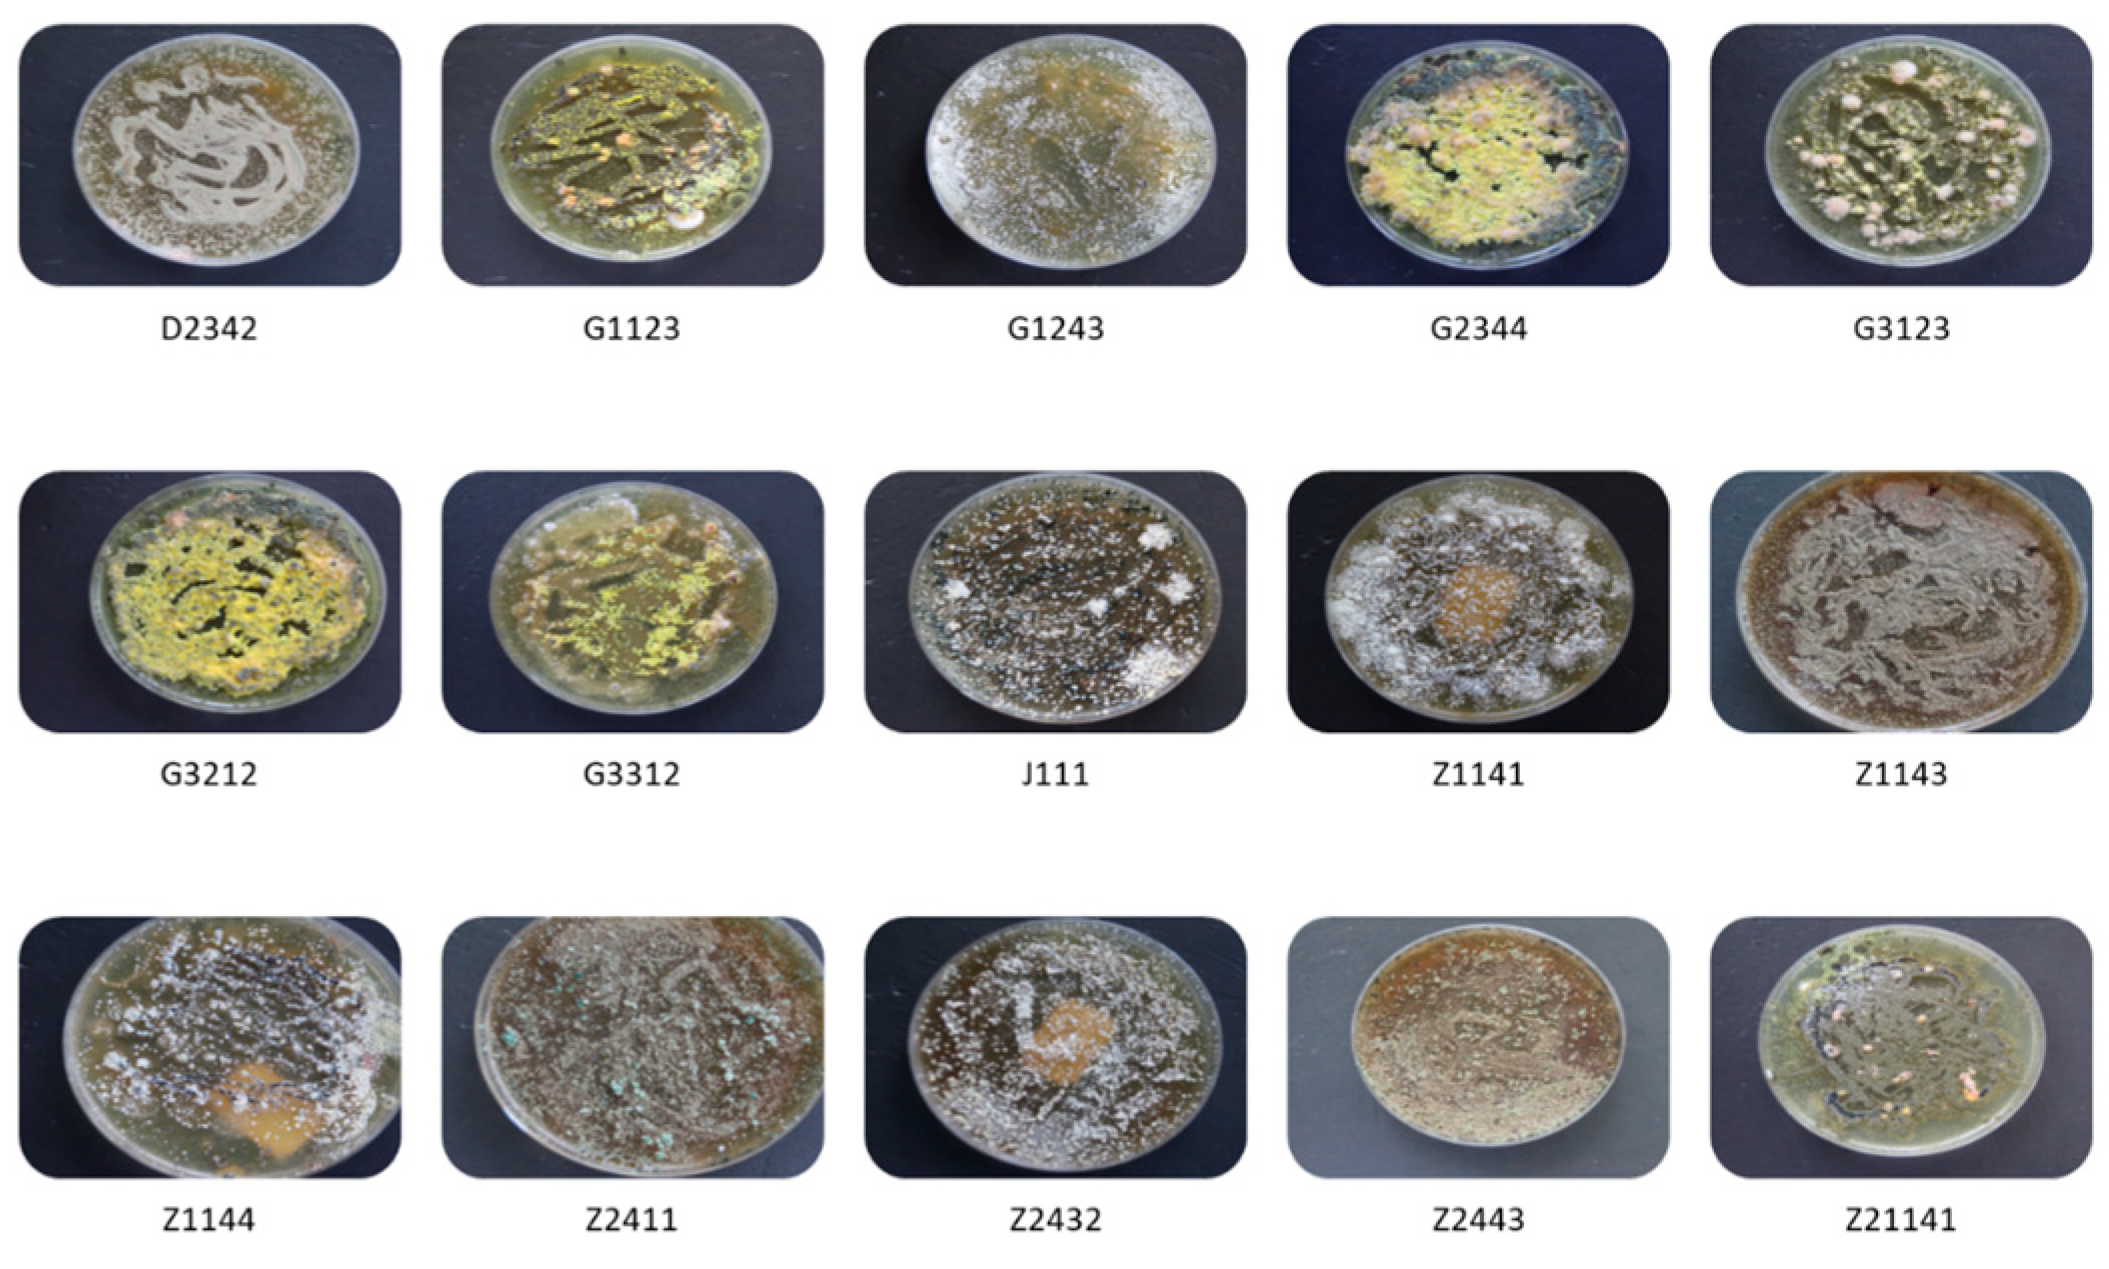
Jof 09 00377 g002 Jof 09 00377 g002

Abstract
Red imported fire ants mounds have been suggested as a potential reservoir for beneficial entomopathogenic fungal species that are vital for more complex roles in the ecosystem aside from infecting the insects. In the current study, the assemblage of fungal symbionts of the red imported fire ants (RIFA) were obtained across five cities in Guangdong Province, China. The sampling areas were selected because of high occurrence of fire ants mounds in the regions. Mound soils, plant debris within mounds, and ants were collected from three sampling locations in each city for potential isolation of entomopathogenic fungal associates of RIFA. All samples were collected during the spring of 2021. Following successful isolation from substrates, the patterns of fungal species composition, and richness were evaluated. In total, 843 isolates were recovered, and based on their phenotypic distinctiveness and molecular characterization based on DNA sequences of multiple loci including the ITS, SSU, and LSU regions, 46 fungal taxa were obtained, including 12 that were unidentified. Species richness and abundance was highest in the mound soils, while the lowest value was recorded from the ant body. As per the different locations, the highest abundance level was recorded in Zhuhai, where 15 fungal taxa were cultivated. The most common taxa across all substrates and locations was Talaromyces diversus. A baseline analysis of the fungal community composition of RIFA would better our understanding on the interactions between these social ants and their associated microbial organisms, and this knowledge in turn would be important for the successful management of the RIFA.
1. Introduction
The microbial communities inhabiting the soil have rich diversity, and their distribution is based on the soil type, climatic conditions, and soil use (i.e., whether the soil is used for agricultural purposes or not) [1]. According to available data, a potential 1.5 million fungal species are contained in the soil, while only about 10% of these abundant microorganisms have been studied until recently [2]. The examined species include entomopathogenic, endophytic, saprophytic, and some edible fungi [3]. For the entomopathogenic species, approximately 90 genera and over 700 species have been reported so far [4,5,6].
Red imported fire ants, Solenopsis invicta Buren (Hymenoptera: Formicidae), are difficult to control due to their aggressiveness, effective foraging, and their ability to mobilize rapidly and actively attack intruders when their mounds are disturbed [7]. These social ants are notorious for invading other exotic and native ant species, which could eventually result in the displacement or elimination of essential native species. It is therefore important to keep a close watch on the activities of these social insects, especially monitoring their rate of dispersal and evaluating the influence of environmental conditions or microbial associates on their development, behavior, survival, etc. These efforts could be of huge importance towards the successful management of the red imported fire ants (RIFA). Insect-associated microorganisms have widely demonstrated the capacity to infect their hosts. Notably, fungi, bacteria, viruses, or virus-like organisms have been reported to cause visible infections in RIFA [8,9].
Baseline analysis of fire ants mounds and plant debris would reveal unique or distinct naturally occurring fungal associates of RIFA. As the microbial species within a microbial population may be beneficial or pathogenic to the hosts, isolation and identification of the associated microbes could help identify potential biological control options for these noxious pests. Arguably, more research works should focus on the diversity of fungi associated with S. invicta, as the currently available data are limited. Tellingly, a previous study suggested RIFA mound soils as a more desirable source of soil-inhabiting fungi. The collected mound soils exhibited a significantly higher abundance of fungi, where roughly 19 times more colony-forming units than the non-mound soils were recorded [10]. However, most previous studies have focused on investigating various entomopathogenic fungal species as potential biocontrol agents for RIFA, while only few studies have conducted surveys to explore the associated microorganisms of RIFA [11]. Survey studies on RIFA microbial associates conducted in China are still limited, while few studies conducted in the United States and some other countries are available [7,10,12,13,14,15,16,17].
The extraction of novel fungal isolates from different soils and other environmental samples has been accomplished using multiple isolation methods. Fungi isolation involving the use of selective media methods is apparently the most common. Meanwhile, several insect-baiting methods have also been widely reported as effective for the isolation of entomopathogenic fungal species [4,18,19,20,21,22]. Some of these aforementioned studies as well as few other RIFA-related studies have revealed that several generalists and entomopathogenic fungi occur in fire ants mounds [7,10,12,13]. However, Woolfolk et al. [14] argued that the data available from most of these studies are somewhat restricted to only a few locations, therefore making the identification of generalist and entomopathogenic fungal associates of the fire ants still relatively unclear. This has therefore raised the need for expanding the available data on fire ants mounds associated fungal microbes. In this vein, an extensive survey of the red imported fire ants’ associated fungal microbes was conducted in the current study. The current study assessed the species richness, diversity, and densities of the culturable fungi associated with RIFA, plant debris within mounds, and mound soils collected from various cities across Guangdong province of China. It is a general opinion that isolating and accurately identifying the RIFA microbial associates would be vital for the effective management of the red imported fire ants.
2. Materials and Methods
2.1. Soil and Ants Sampling
During the spring of 2021, soil samples were collected from fire ant mounds from selected locations across five cities, namely Dongguan, Guangzhou, Huizhou, Jiangmen, and Zhuhai, located within Guangdong Province of China (Figure 1).
Figure 1.
Diagrammatical representation of experimental layout, detailing the various sources of isolation and sampling locations for baseline analysis of fungal associates of RIFA.
From each of the five cities, soil samples were collected from three randomly selected mounds. For individual sampling, approximately 500 g of soil was collected from each mound, taken at about 10–15 cm below the surface using a sterilized hand shovel. The soil samples were transported to the laboratory for analysis in sealed plastic bags.
2.2. Procedure for Fungi Isolation from Samples
Media preparation: The selective media method was deployed for the isolation of fungal isolates from collected samples. First, 40.1 g of potato dextrose agar (PDA; Guangdong Huankai Microbial Sci. and Tech. Co., Ltd., Guangzhou, China) was dissolved in 1 L of distilled water and was amended with 100 mg/L tetracycline hydrochloride (Sangon) and 300 mg/L streptomycin sulfate (Sangon) to inhibit bacteria growth.
Isolation from soil samples: Prior to microbial isolation, existing clumps and stones were carefully removed from soils using a 2 mm pore sieve. Following the procedure of Dhar et al. [23], about 50 g of soil per individual mound was suspended in 500 mL sterile distilled water and vortexed at 200 rpm for approximately 25–30 min on a rotary shaker at room temperature, enabling the fungal spores present in the soil to be dislodged. This procedure was followed by allowing the soil particles to settle for about 15–20 min, and from the third serial dilution of the supernatant, 100 μL of solution was evenly spread on PDA solid media using a sterile disposable cell spreader. Inoculated plates were transferred into a BOD incubator (BS-1E, China) and incubated at 25 °C for 5 days.
Isolation from mound plant debris: Plant debris were removed from soil, and remnant soils were carefully removed using a brush. The remaining soil clogs were removed from the plant tissues by washing them in sterile distilled water for approximately 1 min. The procedures described by Woolfolk et al. [14] were followed for fungi isolation from plant samples. Plates were supplemented with antibiotics to minimize contamination and incubated for 5 days, as previously described.
Isolation from ant bodies: The isolation procedure was carried out following the guidelines of Baird et al. [7] with slight modifications. In the current study, 24 ants were selected per mound, while each individual media plate received 4 ants (a total of 6 plates per mound). Plates were also supplemented with antibiotics and incubated under similar conditions as previously described. All fungal mycelium emerging from the ant tissues were subsequently sub-cultured in fresh growth medium for up to four weeks until monocultures for all fungal isolates were cultivated.
2.3. Morphological Characterization
Following multiple sub-culturing, the monocultures were identified on the basis of their phenotypic distinctiveness prior to phylogenetic characterization. Morphological characterization of fungal strains followed the protocols as described by Humber [24]. Further characterization was performed following the guidelines of Meyer et al. [25], where an optical microscope system equipped with a digital camera was used to analyze the mycelia, conidia, and sporulation structures of individual fungal isolates.
2.4. Molecular Identification
Extraction of genomic DNA from fungal cultures (about 7 days old) was completed with the help of genomic DNA extraction kits (Rapid Fungi Genomic DNA Isolation Kit) provided by the manufacturer (Sangon, Shanghai, China). Extracted DNA was amplified using targeted regions specific primers as follows (Table 1).
Table 1.
List of primer pairs selected for fungal DNA fragments amplification.
The PCR procedure includes a 50 μL reaction mix containing 25.0 μL of 2× High-Fidelity PCR MasterMix (Tiangen Biotech, Shanghai, China), 2.0 μL of each primer pairs, 3.0 μL of DNA template, and 18.0 μL PCR-grade water. The PCR conditions set for fungal DNA amplification was strictly in accordance to the guidelines of the manufacturer. Visualization of amplified DNA was completed on 1.0% m/v agarose gel, and Sanger sequencing was conducted by Sangon Biotech Co. Ltd. Guangzhou, China.
2.5. Phylogenetic Analysis
BioEdit v 7.1.9. [26] was utilized to manually edit the obtained fungal sequence traces, while multiple loci were edited and aligned using Clustal W [27]. With the help of BLASTn, the reference sequences were downloaded from the GenBank database of the National Center for Biotechnology Information (NCBI) (http://www.ncbi.nlm.nih.gov/—accessed on 25 February 2023). In addition, we performed phylogenetic analysis using the sequences produced for the present study and the reference sequences. Neighbor-joining method was deployed for the analysis of sequences based on the maximum composite likelihood via MEGA v. 11.
2.6. Statistical Analysis
Using the frequencies of isolation, the biodiversity indices of fungal samples were determined in accordance with a few of the previously described procedures [7,28,29]. Statistical analysis was performed to determine index of diversity (H’), species richness (n), and evenness (J’). Consequently, diversity of fungal species was calculated via Shannon–Wiener index (H’), which was computed as follows: H’ = ∑ PiInPi, Pi = Ni/Nt, where Ni denotes the value for isolates that belong to the i-th genus, while Nt on the other hand represents the value for isolates in the group of interest (i.e., sampling sites or substrates). In addition, the community coefficient (CC) was computed using the following formulae: CC = C/(S_1 + S_2 − C). Here, C represents the value of unique fungal species that is common to both substrates/location under study, while S_1 and S_2 denote the values for fungal species in individual community, i.e., substrate/location 1 and substrate/location 2, respectively.
When required, one-way analysis of variance (ANOVA) was used for data analysis. The least-significance difference (LSD) test at p < 0.05 was employed to perform multiple comparison among treatment means.
3. Results
3.1. Morphological Characterization of Fungal Isolates
Following multiple sub-culturing until unique cultures were cultivated for all fungal isolates, morphological identification was conducted to determine their distinctive phenotypic features (Figure 2).
Figure 2.
Representative samples of the purified fungal isolates extracted from fire ants, mound soils, and plant debris. Samples were collected across five different cities in Guangdong Province, China.
3.2. Molecular Identification and Phylogenetic Placement of Isolates
In addition to morphological characterization, the successful classification of isolates into specific fungal taxa was achieved by molecular identification based on DNA sequences of multiple loci and phylogenetic characterization. In total, 34 fungal taxa were identified, while 12 isolates are yet to be identified. Phylogenetic characterization was carried out using the combined dataset of three loci (SSU + LSU + ITS) while obtaining supplementary sequences available in the database of NCBI (Figure 3). The DNA sequences derived in the current study can be found in GenBank, and the accession numbers are provided (Table 2).
Figure 3.
Phylogenetic analysis based on a combined dataset sequence of ITS, 18s, and 28s partial sequences of the characterized fungal isolates. Neighbor-joining method was utilized to infer the evolutionary history, while the evolutionary distances were computed using maximum composite likelihood method. The optimal tree is shown. This analysis involved 92 nucleotide sequences and 273 positions in the final dataset. The fungal taxa used in this study are highlighted with black dots. Evolutionary analyses were conducted in MEGA11.
Table 2.
Fungal taxa characterized from different substrates collected from five cities of Guangdong Province of China.
3.3. Assessment of Fungal Species Richness, Diversity, and Densities
For the assessment of fungal species richness, diversity, and densities, fungal isolates were classified into two sub-groups, i.e., sampling sources and locations. In general, the isolation percentage across the fungal taxa varied from 3.9% to 26.5%, and about 24.1% were unidentified. Across various cities and substrates, T. diversus was the most commonly extracted taxa at 26.5%. Other taxa with the greatest percent isolation frequencies include T. pinophilus (12.8%), T. minioluteus (8.3%), and A. flavus (6.4%). The identified taxa were unevenly distributed across the three examined environmental samples: soil (71.7%), plant debris (21.7%), and ant bodies (6.5%) (Figure 4).
Figure 4.
The distribution of fungal taxa across substrates: ant body, plant debris, and mound soils. Bars (±SE) with different letters designate significant differences at p < 0.05 (LSD after one-way ANOVA.
Among the fungal species, only T. diversus (62.5%) and T. pinophilus (37.5%) were successfully isolated from the ant body, while the predominant fungal species across plant debris was T. diversus. All fungal species were successfully isolated from soil samples, where A. flavus and T. minioluteus were only obtained from soils and not from any other substrates. Only T. diversus and T. pinophilus were recorded across all substrates. Following the analysis of sampling locations and environmental samples, the results show that the highest taxa abundance values were from mound soils (33) and Zhuhai (15), respectively (Figure 5).
Figure 5.
Endophytic fungal taxa cultivated from different substrates collected from five different cities of Guangdong Province, China.
For diversity of species assessment using Shannon’s diversity index, the values for fungal species diversity were 1.49 (H’) and 0.75 (H’) across cities and substrates, respectively. On the other hand, the evenness of fungal species was 0.92 (J’) and 0.68 (J’) across cities and substrates, respectively (Table 3). With regards to the coefficient of community values obtained for fungal species across five different locations and the three substrates examined, values ranged from 0.29 to 0.57 (Table 4). For locations such as Zhuhai, Dongguan, and Huizhou, computed CC values for all paired substrates, namely ant body vs. plant debris, ant body vs. mound soil, or plant debris vs. mound soil, were 0.0, as the fungal species recorded across different substrates were not similar. For other locations, namely Jiangmen and Guangzhou, CC values ranged from 0.33 to 1.0 and 0.00 to 0.33, respectively (Table 5).
Table 3.
Fungal taxa abundance, evenness, richness of species, and diversity index across sampling locations and substrates.
Table 4.
The community coefficient (CC) of fungal taxa cultivated from different substrates.
Table 5.
The community coefficient (CC) of fungal taxa cultivated from different substrates within the individual sampling location.
4. Discussion
The current study conducted a baseline analysis of fungal community assemblage in RIFA mounds across five cities located within Guangdong Province, China. The quest to expand the available data on potential biological control agents of RIFA has been one of the major motivation for conducting scientific studies related to insect-hosts-associated microbe interactions. The diversity, richness, and densities of fungal associates of RIFA mounds were examined across ant body, mound soils, and plant debris within the mounds.
The results revealed unevenness in the distribution of fungal species within substrates and across various locations examined. Among the fungal species, the highest species richness values and abundance (total isolations) were recorded in the mound soils, while the rate was lower for ant body and mound plant debris. With regards to the isolation sites, the highest fungal species richness value was recorded in the samples collected from Dongguan and Guangzhou, while the fungal taxa abundance level was highest in the samples collected from Zhuhai.
The overall high value of species richness from soil samples was similar to the study of Woolfolk et al. [14], where evidence of fungal species richness in mound soils at a significantly higher level than in plant debris within the mound and ant body was provided. Similarly, another study conducted by Baird et al. [7] also reported the highest total species richness values in the mound soils, which was significantly higher than values recorded for ant bodies and plant debris within mound soils.
The current study reveals a successful isolation of some beneficial ant–fungal associates, where the most commonly isolated taxa across all substrates and locations are T. diversus, T. pinophilus, A. flavus, and T. asperellum. Most of the identified fungal species could be classified as generalists, while only a few have previously been reported as insect pathogenic fungi. For instance, A. flavus in Aphis fabae [30], P. citrinum in Spodoptera frugiperda [31], and T. asperellum [32]. The possibility of some species of entomopathogenic fungi existing within the RIFA mound has been reported. For instance, in a related study, the cosmopolitan insect pathogenic fungus Beauveria bassiana (Balsamo) Vuillemin was successfully isolated from mound soils, plant debris within mound soils, and ant bodies [7]. Similarly, two other common insect pathogenic fungi, i.e., Purpureocillium lilacinum and Metarhizium anisopliae (Metschnikoff) Sorokin, were isolated from mound soils, mounds plant debris, and ant bodies by Woolfolk et al. [14]. These two studies are similar to several other related studies where a larger percentage of the cultured fungi belong to the artificial assemblage fungi imperfecti (Deuteromycetes), while the majority were documented as non-pathogenic fungal species [10,13,33].
The findings of the present study are similar to numerous other studies that have revealed the possibility of fire ant mounds serving as a good source of important or beneficial microbial symbionts of RIFA [7,14,34]. However, the specific roles played by the fungal species characterized in the current study in RIFA populations regulating and other environmental processes are yet to be clearly defined. For example, the definite interactions between RIFA and T. diversus, which was the most abundant species across all examined substrates and locations, have not been adequately documented in the literature, whereas a number of fungal species that exist as microbial associates of ant mounds have been reported with the potential of naturally regulating colony populations. This possibility was reported in Paecilomyces lilacinus [7]. This fungus draws advantage from its ability to survive in a wide range of agricultural ecosystems as a saprophyte, entomopathogen, as well as nematophagous [35]. Similarly, a number of Fusarium species are also known for their saprophytic lifestyles, where they can exist as opportunists on plant debris within mound soils or as plant parasites in many living plant species, although their effects or benefits on S. invicta or their mounds have not been well documented [14]. As fungal species are able to survive in various habitats, their existence in fire ant mounds has been suggested to be secondary [7]. This is similar to many fungal species that have been classified as rhizosphere-competent, hence their ability to colonize and survive in variety of soils across different regions [19]. It has also been found that certain fungal associates of the RIFA could display a host-protective mechanism against foreign insect pathogenic fungi. This was evident in RIFA colonies’ association with Hypocrea lixii, which appears to protect the ants colonies from being colonized by other entomopathogenic fungi such as B. bassiana or M. anisopliae [14].
Most of the fungal species classified in the current study have previously been isolated from various soil types (including mound and non-mound soils and cultivated and non-agricultural soils), regions, or habitats (including agricultural and forest systems). Moreover, a few species have been reported as phytopathogens of cultivated crops in many agricultural ecosystems. For instance, P. citrinum and A. flavus have both been reported as saprophytes with the ability to colonize plant debris within the soil as well as existing as plant parasites, serving as causal organisms of several plant infections [36,37,38,39]. Although the cultured fungal species have demonstrated the ability to survive in different soil types and habitats., some previous studies have provided evidence of ant mound soils with greater abundance or richness in fungal species in comparison to non-mound soils. For instance, Zettler et al. [10] found about 19 times more colony-forming units in mound soils, although lower fungal species richness and diversity was reported in the mound soils. On the other hand, Woolfolk et al. [14] suggested that the habitat or geographical location of the isolation sites could exert much more influence on fungal species abundance than the ant colonies. In addition, temperature, PH, rainfall, and several other environmental conditions have been reported to greatly affect fungal diversity within RIFA mounds [10].
5. Conclusions
The current findings reveal the existence of diverse fungal species within the RIFA mound soils, plant remnants deposited within the mound, and the body of ants. The identified fungal species were found to be unevenly distributed across the substrates and locations examined. Several entomopathogenic fungal species such as B. bassiana, M. anisopliae, and P. lilacinum have been found existing within the RIFA mounds, where they could play the role of colony population regulators by nature. However, none of these three insect pathogenic species was successfully recovered in the current study. Notably, few of the species recorded in this study have been reported as insect pathogenic fungi in some insects. The specific roles played by the cultured fungal species in RIFA survival, growth, invasion, and other ecological functions are still relatively unknown. Future research should be focused in this direction.
Author Contributions
Conceptualization, B.S.B. and Y.X.; formal analysis, B.S.B., L.C.R.A. and A.I.; funding acquisition, B.S.B. and Y.X.; investigation, B.S.B. and J.A.S.; project administration, C.J. and Y.X.; resources, L.N.; supervision, Y.X.; writing—original draft, B.S.B., J.A.S. and A.I.; writing—review and editing, Y.X. All authors have read and agreed to the published version of the manuscript.
Funding
This study was supported by the Research Fund for International Young Scientists (32150410344), a research grant received from National Natural Science Foundation of China (NSFC).
Data Availability Statement
Data supporting the results can be found in NCBI’s GenBank database following this link—http://www.ncbi.nlm.nih.gov/—accessed on 25 February 2023.
Acknowledgments
We are grateful to all of our colleagues at the Red Imported Fire Ants Research Centre of South China Agricultural University, Guangzhou, China, for their assistance in samples collection, culture media preparation, and procurement of experimental items used for the study.
Conflicts of Interest
The authors declare that they have no conflict of interest. The funders had no role in the design of the study; in the collection, analyses, or interpretation of data; in the writing of the manuscript or in the decision to publish the results.
References
- Orgiazzi, A.; Dunbar, M.B.; Panagos, P.; de Groot, G.A.; Lemanceau, P. Soil biodiversity and DNA barcodes: Opportunities and challenges. Soil Biol. Biochem. 2015, 80, 244–250. [Google Scholar] [CrossRef]
- Hawksworth, D.L. The magnitude of fungal diversity: The 1.5 million species estimate revisited. Mycol. Res. 2001, 105, 1422–1432. [Google Scholar] [CrossRef]
- Hirsch, J.; Galidevara, S.; Strohmeier, S.; Devi, K.U.; Reineke, A. Effects on diversity of soil fungal community and fate of an artificially applied Beauveria bassiana strain assessed through 454 pyrosequencing. Microb. Ecol. 2013, 66, 608–620. [Google Scholar] [CrossRef] [PubMed]
- Bamisile, B.S.; Akutse, K.S.; Siddiqui, J.A.; Xu, Y. Model application of entomopathogenic fungi as alternatives to chemical pesticides: Prospects, challenges, and insights for next-generation sustainable agriculture. Front. Plant Sci. 2021, 12, 741804. [Google Scholar] [CrossRef]
- Khachatourians, G.G.; Qazi, S.S. Entomopathogenic fungi: Biochemistry and molecular biology. In Human and Animal Relationships; Springer: Berlin/Heidelberg, Germany, 2008; pp. 33–61. [Google Scholar]
- Onofre, S.B.; Miniuk, C.M.; de Barros, N.M.; Azevedo, J.L. Pathogenicity of four strains of entomopathogenic fungi against the bovine tick Boophilus microplus. Am. J. Vet. Res. 2001, 62, 1478–1480. [Google Scholar] [CrossRef]
- Baird, R.; Woolfolk, S.; Watson, C. Survey of bacterial and fungal associates of black/hybrid imported fire ants from mounds in Mississippi. Southeast Nat. 2007, 6, 615–632. [Google Scholar] [CrossRef]
- Valles, S.M.; Strong, C.A. Solenopsis invicta virus-1A (SINV-1A): Distinct species or genotype of SINV-1? J. Invertebr Pathol. 2005, 88, 232–237. [Google Scholar] [CrossRef]
- Valles, S.M.; Strong, C.A.; Dang, P.M.; Hunter, W.B.; Pereira, R.M.; Oi, D.H.; Shapiro, A.M.; Williams, D.F. A picorna-like virus from the red imported fire ant, Solenopsis invicta: Initial discovery, genome sequence, and characterization. Virology 2004, 328, 151–157. [Google Scholar] [CrossRef]
- Zettler, J.A.; Mcinnis Jr, T.M.; Allen, C.R.; Spira, T.P. Biodiversity of fungi in red imported fire ant (Hymenoptera: Formicidae) mounds. Ann. Entomol Soc. Am. 2002, 95, 487–491. [Google Scholar] [CrossRef]
- Williams, D.F.; Oi, D.H.; Porter, S.D.; Pereira, R.M.; Briano, J.A. Biological control of imported fire ants (Hymenoptera: Formicidae). Am. Entomol. 2003, 49, 150–163. [Google Scholar] [CrossRef]
- Beckham, R.; Bilimoria, S.; Bartell, D. A survey for microorganisms associated with ants in western Texas. Southwest Entomol. 1982, 7, 225–229. [Google Scholar]
- Jouvenaz, D.; Allen, G.; Banks, W.; Wojcik, D.P. A survey for pathogens of fire ants, Solenopsis spp., in the southeastern United States. Florida Entomol. 1977, 60, 275–279. [Google Scholar] [CrossRef]
- Woolfolk, S.; Stokes, C.E.; Watson, C.; Baker, G.; Brown, R.; Baird, R. Fungi associated with Solenopsis invicta Buren (Red imported fire ant, Hymenoptera: Formicidae) from mounds in Mississippi. Southeast Nat. 2016, 15, 220–234. [Google Scholar] [CrossRef]
- Woolfolk, S.; Stokes, C.E.; Watson, C.; Brown, R.; Baird, R. Bacteria associated with red imported fire ants (Solenopsis invicta) from mounds in Mississippi. Southeast Nat. 2016, 15, 83–101. [Google Scholar] [CrossRef]
- Ishak, H.D.; Plowes, R.; Sen, R.; Kellner, K.; Meyer, E.; Estrada, D.A.; Dowd, S.E.; Mueller, U.G. Bacterial diversity in Solenopsis invicta and Solenopsis geminata ant colonies characterized by 16S amplicon 454 pyrosequencing. Microb. Ecol. 2011, 61, 821–831. [Google Scholar] [CrossRef]
- Powell, C.M.; Hanson, J.D.; Bextine, B.R. Bacterial community survey of Solenopsis invicta Buren (red imported fire ant) colonies in the presence and absence of Solenopsis invicta virus (SINV). Curr. Microbiol. 2014, 69, 580–585. [Google Scholar] [CrossRef]
- Ahmed, A.A.I.; Khalil, S.S.H.; Sahab, A.F. Identification and evaluation of isolated entomopathogenic fungus from Egyptian soil against the black cutworm larvae of Agrotis ipsilon (Hufnagel) (Lepidoptera: Noctuidae). Egypt. J. Biol. Pest Control 2022, 32, 67. [Google Scholar] [CrossRef]
- Cabrera-Mora, J.; Guzmán-Franco, A.; Santillán-Galicia, M.; Tamayo-Mejía, F. Niche separation of species of entomopathogenic fungi within the genera Metarhizium and Beauveria in different cropping systems in Mexico. Fungal Ecol. 2019, 39, 349–355. [Google Scholar] [CrossRef]
- López Plantey, R.; Papura, D.; Couture, C.; Thiéry, D.; Pizzuolo, P.H.; Bertoldi, M.V.; Lucero, G.S. Characterization of entomopathogenic fungi from vineyards in Argentina with potential as biological control agents against the European grapevine moth Lobesia botrana. BioControl 2019, 64, 501–511. [Google Scholar] [CrossRef]
- Muñiz-Reyes, E.; Guzmán-Franco, A.; Sánchez-Escudero, J.; Nieto-Angel, R. Occurrence of entomopathogenic fungi in tejocote (Crataegus mexicana) orchard soils and their pathogenicity against Rhagoletis pomonella. J. Appl. Microbiol. 2014, 117, 1450–1462. [Google Scholar] [CrossRef]
- Pérez-González, V.H.; Guzmán-Franco, A.W.; Alatorre-Rosas, R.; Hernández-López, J.; Hernández-López, A.; Carrillo-Benítez, M.G.; Baverstock, J. Specific diversity of the entomopathogenic fungi Beauveria and Metarhizium in Mexican agricultural soils. J. Invertebr. Pathol. 2014, 119, 54–61. [Google Scholar] [CrossRef] [PubMed]
- Dhar, S.; Jindal, V.; Jariyal, M.; Gupta, V. Molecular characterization of new isolates of the entomopathogenic fungus Beauveria bassiana and their efficacy against the tobacco caterpillar, Spodoptera litura (Fabricius) (Lepidoptera: Noctuidae). Egypt J. Biol. Pest Co. 2019, 29, 8. [Google Scholar] [CrossRef]
- Humber, R.A. Identification of entomopathogenic fungi. Manual Tech. Invertebr. Pathol. 2012, 151–187. [Google Scholar]
- Meyer, J.M.; Hoy, M.A.; Boucias, D.G. Isolation and characterization of an Isaria fumosorosea isolate infecting the Asian citrus psyllid in Florida. J. Invertebr. Pathol. 2008, 99, 96–102. [Google Scholar] [CrossRef]
- Hall, T.A. BioEdit: A User-Friendly Biological Sequence Alignment Editor and Analysis Program for Windows 95/98/NT; Information Retrieval Ltd.: London, UK, 1999; pp. 95–98. [Google Scholar]
- Thompson, J.D.; Gibson, T.J.; Plewniak, F.; Jeanmougin, F.; Higgins, D.G. The CLUSTAL_X windows interface: Flexible strategies for multiple sequence alignment aided by quality analysis tools. Nucleic Acids Res. 1997, 25, 4876–4882. [Google Scholar] [CrossRef]
- Inglis, G.; Cohen, A. Influence of antimicrobial agents on the spoilage of a meat-based entomophage diet. J. Econ. Entomol. 2004, 97, 235–250. [Google Scholar] [CrossRef]
- Woolfolk, S.W.; Inglis, G.D. Microorganisms associated with field-collected Chrysoperla rufilabris (Neuroptera: Chrysopidae) adults with emphasis on yeast symbionts. Biol. Control 2004, 29, 155–168. [Google Scholar] [CrossRef]
- Boni, S.B.; Mwashimaha, R.A.; Mlowe, N.; Sotelo-Cardona, P.; Nordey, T. Efficacy of indigenous entomopathogenic fungi against the black aphid, Aphis fabae Scopoli under controlled conditions in Tanzania. Int. J. Trop. Insect Sci. 2021, 41, 1643–1651. [Google Scholar] [CrossRef]
- Hernandez-Trejo, A.; Estrada-Drouaillet, B.; López-Santillán, J.; Rios-Velasco, C.; Varela-Fuentes, S.; Rodríguez-Herrera, R.; Osorio-Hernández, E. In vitro evaluation of native entomopathogenic fungi and neem (Azadiractha indica) extracts on Spodoptera frugiperda. Phyton 2019, 88, 47. [Google Scholar]
- Wu, Q.; Sun, R.; Ni, M.; Yu, J.; Li, Y.; Yu, C.; Dou, K.; Ren, J.; Chen, J. Identification of a novel fungus, Trichoderma asperellum GDFS1009, and comprehensive evaluation of its biocontrol efficacy. PLoS ONE 2017, 12, e0179957. [Google Scholar] [CrossRef]
- Briano, J.; Jouvenaz, D.; Wojcik, D.; Cordo, H.; Patterson, R. Protozoan and fungal diseases in Solenopsis richteri and S. quinquecuspis (Hymenoptera: Formicidae) in Buenos Aires Province, Argentina. Florida Entomol. 1995, 78, 531. [Google Scholar]
- Bamisile, B.S.; Nie, L.; Siddiqui, J.A.; Ramos Aguila, L.C.; Akutse, K.S.; Jia, C.; Xu, Y. Assessment of mound soils bacterial community of the red imported fire ant, Solenopsis invicta across Guangdong province of China. Sustainability 2023, 15, 1350. [Google Scholar] [CrossRef]
- Atkins, S.D.; Clark, I.M.; Pande, S.; Hirsch, P.R.; Kerry, B.R. The use of real-time PCR and species-specific primers for the identification and monitoring of Paecilomyces lilacinus. FEMS Microbiol. Ecol. 2005, 51, 257–264. [Google Scholar] [CrossRef] [PubMed]
- Scheidegger, K.; Payne, G. Unlocking the secrets behind secondary metabolism: A review of Aspergillus flavus from pathogenicity to functional genomics. J. Toxicol: Toxin Rev. 2003, 22, 423–459. [Google Scholar] [CrossRef]
- Dobson, A. Yeasts and Molds | Aspergillus flavus. In Encyclopedia of Dairy Sciences, 2nd ed.; Elsevier: Amsterdam, The Netherlands, 2011; pp. 785–791. [Google Scholar] [CrossRef]
- Cleveland, T.E.; Yu, J.; Fedorova, N.; Bhatnagar, D.; Payne, G.A.; Nierman, W.C.; Bennett, J.W. Potential of Aspergillus flavus genomics for applications in biotechnology. Trends Biotechnol. 2009, 27, 151–157. [Google Scholar] [CrossRef]
- Litoriya, N.S.; Modi, A. Mycotoxin-associated food safety concerns of agriculture crops. In Food Security and Plant Disease Management; Elsevier: Amsterdam, The Netherlands, 2021; pp. 149–169. [Google Scholar]
Disclaimer/Publisher’s Note: The statements, opinions and data contained in all publications are solely those of the individual author(s) and contributor(s) and not of MDPI and/or the editor(s). MDPI and/or the editor(s) disclaim responsibility for any injury to people or property resulting from any ideas, methods, instructions or products referred to in the content. |
© 2023 by the authors. Licensee MDPI, Basel, Switzerland. This article is an open access article distributed under the terms and conditions of the Creative Commons Attribution (CC BY) license (https://creativecommons.org/licenses/by/4.0/).